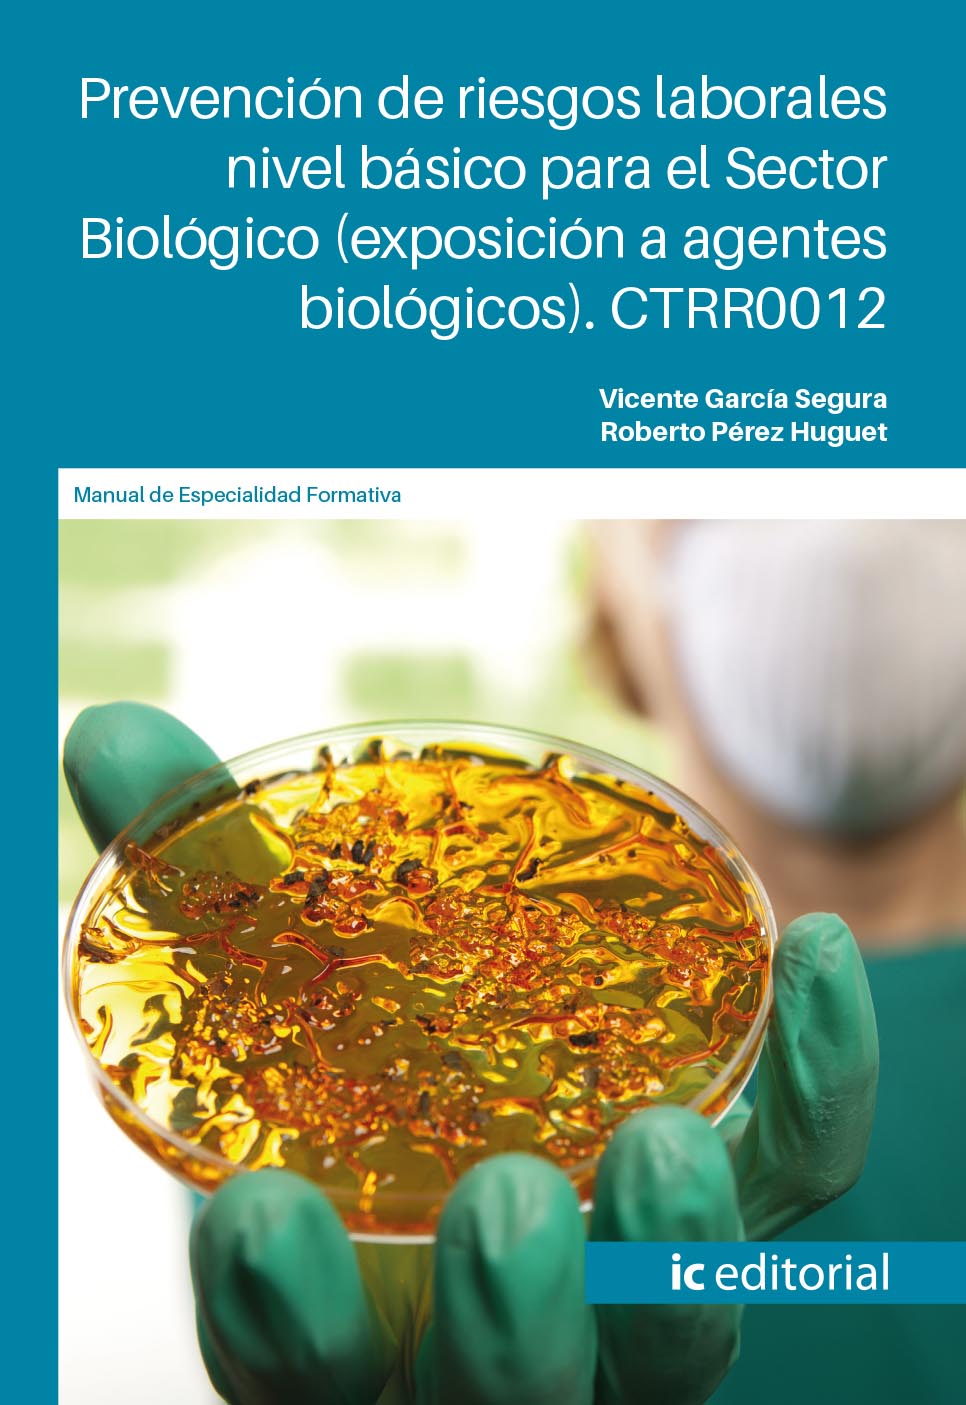
Prevención de riesgos laborales nivel básico para el Sector Biológico (exposición a agentes biológicos). CTRR0012

Manipulación y movimientos con transpalés y carretillas de mano. COMT0211 - Actividades auxiliares de comercio
Vicente García Segura y Carlos Alberto Torres GómezEditorial: IC EditorialISBN: 9788491987901

Sinopsis
Objetivos - Diferenciar las funciones y características de los equipos de trabajo móviles, transpalés, manuales y eléctricos, y carretillas de mano utilizados habitualmente en la manipulación y movimientos de productos. - Conducir transpalés y carretillas de mano, con seguridad y eficacia, a partir deórdenes de movimiento y reparto, realizando distintas maniobras y garantizando la estabilidad de la carga. - Adoptar las medidas y recomendaciones de seguridad y salud en la manipulación y movimiento de cargas con equipos de trabajo móvil sencillos, en base a las normas específicas de seguridad y salud. - Interpretar la señalización y normas de circulación al manejar equipos de trabajo móvil, transpalé o carretilla de mano en distintas superficies o espacios de trabajo. - Diferenciar los elementos y criterios a considerar en el recorrido/ruta de reparto de proximidad, a partir de distintas órdenes de reparto o movimiento. - Aplicartécnicas y pautas específicas de mantenimiento de primer nivel y detecciónde anomalías de transpalés carretillas u otro equipo de trabajo móvil sencillo, de acuerdo con las especificaciones del fabricante. Contenidos Operativa y documentación de movimiento y reparto de proximidad Introducción Documentación básica de órdenes de movimiento Operativa de las órdenes de trabajo y movimiento: eficiencia y eficacia Movimientos dentro y fuera de la superficie comercial Órdenes de reparto de proximidad Normas y recomendaciones de circulación, carga y descarga Resumen Conducción de transpalés y carretillas de mano Introducción Tipos y características de los equipos de trabajo móviles Localización de los elementos del equipo de trabajo Optimización de tiempo y espacio Colocación y estabilidad de la carga Simulación de maniobras en el movimiento de cargas con equipos de trabajo móvil Resumen Mantenimiento de primer nivel de transpalés y carretillas de mano Introducción Pautas de comportamiento y verificación en el mantenimiento de transpalés y carretillas de mano Herramientas y material de limpieza de los equipos Recomendaciones básicas de mantenimiento de equipos del fabricante Sistema hidráulico y de elevación Cambio y carga de baterías Comprobación rutinaria y mantenimiento básico de transpalés y carretillas de mano Simulación de operaciones de mantenimiento de primer nivel Resumen Seguridad y prevención de accidentes y riesgos laborales en la manipulación de equipos de trabajo móviles Introducción Normas y recomendaciones de seguridad Normas de seguridad y salud en el movimiento de productos Higiene postural y equipo de protección individual en la manipulación de productos Medidas de actuación en situaciones de emergencia Resumen
Otros libros de Vicente García Segura
-

1782. Prevención de riesgos laborales. Administración y gestión
Vicente García SeguraIC Editorial -

1782. Prevención de riesgos laborales. Servicios socioculturales y a la comunidad
Vicente García SeguraIC Editorial -

1782. Prevención de riesgos laborales. Comercio y marketing
Vicente García SeguraIC Editorial -

Prevención de riesgos laborales nivel básico para el Sector Sanitario. CTRR0012
Vicente García SeguraIC Editorial -

Prevención de riesgos laborales nivel básico para el Sector Obras (construcción, excavación, movimientos de tierras y túneles). CTRR0012
Vicente García SeguraIC Editorial -

Prevención de riesgos laborales nivel básico para el Sector Químico. CTRR0012
Vicente García SeguraIC Editorial -

Prevención de riesgos laborales nivel básico para el Sector Explosivos. CTRR0012
Vicente García SeguraIC Editorial -
Prevención de riesgos laborales nivel básico para el Sector Biológico (exposición a agentes biológicos). CTRR0012
Vicente García SeguraIC Editorial -

Prevención de riesgos laborales nivel básico para el Sector Alta Tensión. CTRR0012
Vicente García SeguraIC Editorial -

Prevención de riesgos laborales en trabajos de soldadura. FMEC0119_2 - Soldadura por arco bajo gas protector con electrodo consumible, soldeo «MIG/MAG»
Vicente García SeguraIC Editorial -

Gestión de la prevención de riesgos laborales en pequeños negocios. COMT0112 - Actividades de gestión del pequeño comercio
Vicente García SeguraIC Editorial -

Básico de Prevención de Riesgos Laborales para el Sector Electricidad. FCOS02
Vicente García SeguraIC Editorial -

Básico de Prevención de Riesgos Laborales para el Sector Agricultura. FCOS02
Vicente García SeguraIC Editorial -

Básico de Prevención de Riesgos Laborales para el Sector Oficina. FCOS02
Vicente García SeguraIC Editorial -

Básico de Prevención de Riesgos Laborales para el Sector Lavandería. FCOS02
Vicente García SeguraIC Editorial -

Básico de Prevención de Riesgos Laborales para el Sector Farmacia. FCOS02
Vicente García SeguraIC Editorial -

Básico de Prevención de Riesgos Laborales para el Sector Peluquería. FCOS02
Vicente García SeguraIC Editorial -

Básico de Prevención de Riesgos Laborales para el Sector Transportes. FCOS02
Vicente García SeguraIC Editorial -

Básico de Prevención de Riesgos Laborales para Centro Infantil. FCOS02
Vicente García SeguraIC Editorial -

Básico de Prevención de Riesgos Laborales para Trabajo en altura. FCOS02
Vicente García SeguraIC Editorial -

Básico de Prevención de Riesgos Laborales para el Sector Limpieza. FCOS02
Vicente García SeguraIC Editorial -

Básico de Prevención de Riesgos Laborales para el Sector Almacén. FCOS02
Vicente García SeguraIC Editorial -

Básico de Prevención de Riesgos Laborales para el Sector Gasolineras. FCOS02
Vicente García SeguraIC Editorial -

Básico de Prevención de Riesgos Laborales para el Sector Hostelería. FCOS02
Vicente García SeguraIC Editorial -

Gestión de la prevención de riesgos laborales en pequeños negocios. ADGD0210 - Creación y gestión de microempresas
Vicente García SeguraIC Editorial -

Manipulación de cargas con carretillas elevadoras. IEXD0108 - Elaboración de la piedra natural
Vicente García SeguraIC Editorial -

Manipulación de cargas con carretillas elevadoras. INAQ0108 - Operaciones auxiliares de mantenimiento y transporte interno de la industria alimentaria
Vicente García SeguraIC Editorial -

Manipulación de cargas con carretillas elevadoras. INAD0108 - Operaciones auxiliares de elaboracion en la industria alimentaria
Vicente García SeguraIC Editorial -

Manipulación de cargas con carretillas elevadoras. COML0110 - Actividades auxiliares de almacén
Vicente García SeguraIC Editorial -

-

Ejecución de fábricas para revestir. EOCB0108 - Fábricas de albañilería
Vicente García SeguraIC Editorial -

Ejecución de fábricas para revestir. EOCB0208 - Operaciones auxiliares de albañilería de fábricas y cubiertas
Vicente García SeguraIC Editorial -

Seguridad y prevención de riesgos en el almacén. COML0309 - Organización y gestión de almacenes
Vicente García SeguraIC Editorial -

Prevención de riesgos laborales básico. Sector limpieza
Vicente García SeguraIC Editorial -

-

Prevención de Riesgos Laborales Básico. Sector Hostelería-Restauración
Vicente García SeguraIC Editorial -

-

Prevención de riesgos laborales básico. Sector lavanderías
Vicente García SeguraIC Editorial -

Prevención de riesgos laborales básico. Sector electricidad
Vicente García SeguraIC Editorial -

Prevención de riesgos laborales básico. Sector farmacias
Vicente García SeguraIC Editorial -

Prevención de riesgos laborales básico. Sector gasolineras y estaciones de servicio
Vicente García SeguraIC Editorial -

-

Prevención de riesgos laborales básico. Trabajo en altura
Vicente García SeguraIC Editorial -

Uso y prevención de riesgos laborales en plataformas elevadoras
Vicente García SeguraIC Editorial -

TPC madera y Mueble - Instalación de carpintería de madera y mueble
Vicente García SeguraIC Editorial -

Seguridad aeronáutica y prevención de riesgos laborales y medioambientales. TMVO0109 - Operaciones auxiliares de mantenimiento aeronáutico
Vicente García SeguraIC Editorial -

TPC Madera y Mueble - Montador de estructuras de madera
Vicente García SeguraIC Editorial -

Prevención de riesgos laborales básico. Sector agricultura
Vicente García SeguraIC Editorial -

Prevención de riesgos laborales y medioambientales en el mecanizado por arranque de viruta. FMEH0109 - Mecanizado por arranque de viruta
Vicente García SeguraIC Editorial
Otros libros de Carlos Alberto Torres Gómez
-

Gestión de la atención al cliente/consumidor. COMV0108 - Actividades de venta
Carlos Alberto Torres GómezIC Editorial -

Gestión de la atención al cliente/consumidor. COMT0110 - Atención al cliente, consumidor o usuario
Carlos Alberto Torres GómezIC Editorial -

Organización de Procesos de Venta. COMT0112 - Actividades de gestión del pequeño comercio
Carlos Alberto Torres GómezIC Editorial -

Organización de procesos de venta. COMV0108 - Actividades de venta
Carlos Alberto Torres GómezIC Editorial -

Organización de Procesos de Venta. COMT0411 - Gestión comercial de ventas
Carlos Alberto Torres GómezIC Editorial -

Venta online. COMT0112 - Actividades de gestión del pequeño comercio
Carlos Alberto Torres GómezIC Editorial -

-

Venta online. COMT0411 - Gestión comercial de ventas
Carlos Alberto Torres GómezIC Editorial -

Gestión de la atención al cliente/consumidor. COMV0108 - Actividades de venta
Carlos Alberto Torres GómezIC Editorial -

Venta online. COMT0112 - Actividades de gestión del pequeño comercio
Carlos Alberto Torres GómezIC Editorial -

Organización de Procesos de Venta. COMT0112 - Actividades de gestión del pequeño comercio
Carlos Alberto Torres GómezIC Editorial -

Operaciones de caja en la venta. COMV0108 - Actividades de venta
Carlos Alberto Torres GómezIC Editorial -

Atención básica al cliente. COMT0211 - Actividades auxiliares de comercio
Carlos Alberto Torres GómezIC Editorial -

-

Gestión del equipo de trabajo del almacén. COML0309 - Organización y gestión de almacenes
Carlos Alberto Torres GómezIC Editorial -

Gestión de acciones comerciales de la actividad de mediación. ADGN0210 - Mediación de seguros y reaseguros privados y actividades auxiliares
Carlos Alberto Torres GómezIC Editorial -

Tratamiento de las quejas y reclamaciones de clientes de servicios financieros. ADGN0210 - Mediación de seguros y reaseguros privados y actividades auxiliares
Carlos Alberto Torres GómezIC Editorial
